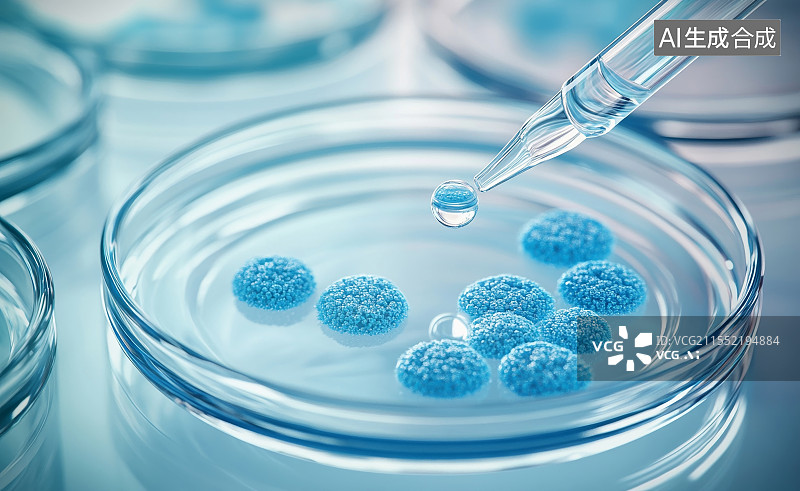

图片
- 图片
- 视频
- 音频
- 字体
【AI数字艺术】细菌培养基菌群检测细菌检测培养皿
【AI数字艺术】细菌培养基菌群检测细菌检测培养皿图片素材作品是由视觉中国旗下网站(VCG.COM)的图片品牌合作方:Shijue AIGC提供,作品作者是:签约供稿人/视觉中国;图片ID:VCG211552194884;最大规格:10000 x 6136 px (300ppi) | TIFF 175.55 MB;存储大小:15.96 MB - JPEG;授权方式是:;当前图片素材提供下载与正版授权服务,助力您的品牌提升。
图片ID:VCG211552194884
作者/来源: 签约供稿人/视觉中国
品牌:Shijue AIGC
最大尺寸:10000 x 6136 px (300ppi) | TIFF 175.55 MB | 84.67 x 51.95 cm (33.33 x 20.45 in.)
存储大小:15.96 MB - JPEG
图片类型:
购买咨询
